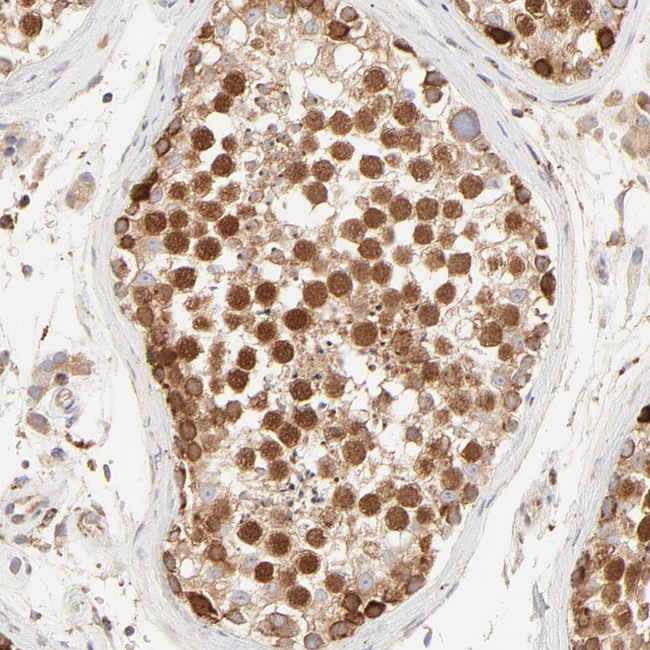
PARP12 Antibody in Immunohistochemistry (Paraffin) (IHC (P))

Search
Invitrogen
PARP12 Polyclonal Antibody
{{$productOrderCtrl.translations['antibody.pdp.commerceCard.promotion.promotions']}}
{{$productOrderCtrl.translations['antibody.pdp.commerceCard.promotion.viewpromo']}}
{{$productOrderCtrl.translations['antibody.pdp.commerceCard.promotion.promocode']}}: {{promo.promoCode}} {{promo.promoTitle}} {{promo.promoDescription}}. {{$productOrderCtrl.translations['antibody.pdp.commerceCard.promotion.learnmore']}}




Please note: We are reviewing Western blot images included in the antibody testing data in our catalog, including those provided by third parties. Unless expressly labeled or annotated as “raw-unedited”, Western blot images included in the antibody testing data in our catalog may have been edited, optimized or otherwise adjusted for presentation.
产品信息
PA5-51967
种属反应
宿主/亚型
分类
类型
抗原
偶联物
形式
浓度
规格
纯化类型
保存液
内含物
保存条件
运输条件
RRID
产品详细信息
Immunogen sequence: AATLKFQAGK HNYELDFKAF VQKNLVYGTT KKVCRRPKYV SPQDVTTMQT CNTKFPGPKS IPDYWDSSAL PDPGFQKITL SSSSEEYQKV WNLFNRTLPF YFVQKIERVQ NLALWEVYQW QKGQMQKQNG G
Highest antigen sequence identity to the following orthologs: Mouse - 85%, Rat - 86%.
靶标信息
Poly(ADP-ribosyl)ation is an immediate DNA-damage-dependent post-translational modification of histones and other nuclear proteins that contributes to the survival of injured proliferating cells. Poly(ADP-ribose) polymerases (PARPs) now constitute a large family of 18 proteins, encoded by different genes and displaying a conserved catalytic domain in which PARP-1 (113 kDa), the founding member, and PARP-2 (62 kDa) are so far the sole enzymes whose catalytic activity has been shown to be immediately stimulated by DNA strand breaks. A large repertoire of sequences encoding novel PARPs now extends considerably the field of poly(ADP-ribosyl)ation reactions to various aspects of the cell biology including cell proliferation and cell death. Some of these new members interact with each other, share common partners and common subcellular localizations suggesting possible fine tuning in the regulation of this post-translational modification of proteins.
仅用于科研。不用于诊断过程。未经明确授权不得转售。
篇参考文献 (0)
生物信息学
蛋白别名: ADP-ribosyltransferase diphtheria toxin-like 12; ARTD12; PARP-12; Poly [ADP-ribose] polymerase 12; Protein mono-ADP-ribosyltransferase PARP12; Zinc finger CCCH domain-containing protein 1
基因别名: PARP12; ZC3HDC1
Entrez Gene ID: (Human) 64761